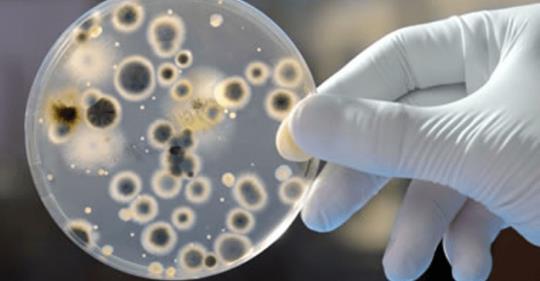

En las últimas horas se ha alertado sobre el peligroso hongo que demostró una resistencia feroz, y está poniendo en riesgo a personas con un sistema inmunológico muy debilitado. Ha sido calificado como una seria amenaza a nivel global por su resistencia a múltiples fármacos, por su difícil identificación con métodos de laboratorios y por causar brotes en entornos sanitarios. En Estados Unidos se ha dado a conocer que este hongo reapareció en diferentes recintos hospitalarios, provocando enfermedades severas e invasivas que afectan la sangre, el corazón y el cerebro.
Los países que han reportado infecciones por este hongo son:
- Canadá
- Venezuela
- Reino Unido
- Alemania
- Francia
- España
- Pakistán
- Japón
- India
- Sudáfrica
Se propaga a través del contacto, sea por manos del personal de salud y el entorno que rodee al paciente. El hongo produce fiebre, dolor y mucha fatiga.